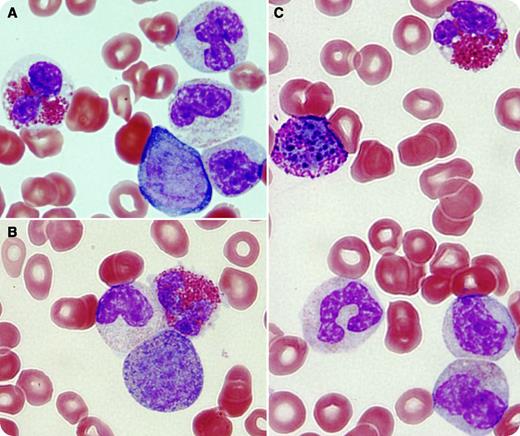
A 35-year-old male presented with a several-weeks history of abdominal discomfort, early satiety, low-grade fever, night sweats, and weight loss. Physical examination revealed pale skin and a massive hepatosplenomegaly. A complete blood count showed severe anemia, thrombocytopenia, and marked leukocytosis (100 000/μL) with 10% blasts, eosinophilia (4000/μL), and basophilia (3000/μL). Peripheral smear demonstrated blasts (panel A), early myeloid precursors (panels A-C), eosinophilia (panels A-C), and basophilia (panel C). Bone marrow biopsy showed myeloid lineage hyperplasia. Cytogenetic analysis was significant for t(8;9)(p22;p24). Testing for JAK2 mutation was negative, and FISH analysis failed to show BCR-ABL1 or any abnormality involving PDGFRA, PDGFRB, or FGFR1 genes. The patient was diagnosed with myeloproliferative neoplasm (MPN)-unclassified after excluding other hematologic neoplasms and causes of eosinophilia/basophilia. / Translocation t(8;9)(p22;p24) has been described to activate JAK2, resulting in a variety of diseases that surpass MPN to include cases of acute leukemia, lymphoma, and myelofibrosis. At the molecular level, t(8;9)(p22;p24) results in a new fusion gene product, putting the pericentriolar material 1 (PCM1) gene located on 8p22 in close proximity with the JAK-2 gene located on 9p24. This results in the continuous activation of JAK2 tyrosine kinase. PCM1-JAK2–positive MPN is a rare disease characterized by an aggressive course and resistance to therapy.

A 35-year-old male presented with a several-weeks history of abdominal discomfort, early satiety, low-grade fever, night sweats, and weight loss. Physical examination revealed pale skin and a massive hepatosplenomegaly. A complete blood count showed severe anemia, thrombocytopenia, and marked leukocytosis (100 000/μL) with 10% blasts, eosinophilia (4000/μL), and basophilia (3000/μL). Peripheral smear demonstrated blasts (panel A), early myeloid precursors (panels A-C), eosinophilia (panels A-C), and basophilia (panel C). Bone marrow biopsy showed myeloid lineage hyperplasia. Cytogenetic analysis was significant for t(8;9)(p22;p24). Testing for JAK2 mutation was negative, and FISH analysis failed to show BCR-ABL1 or any abnormality involving PDGFRA, PDGFRB, or FGFR1 genes. The patient was diagnosed with myeloproliferative neoplasm (MPN)-unclassified after excluding other hematologic neoplasms and causes of eosinophilia/basophilia.
Translocation t(8;9)(p22;p24) has been described to activate JAK2, resulting in a variety of diseases that surpass MPN to include cases of acute leukemia, lymphoma, and myelofibrosis. At the molecular level, t(8;9)(p22;p24) results in a new fusion gene product, putting the pericentriolar material 1 (PCM1) gene located on 8p22 in close proximity with the JAK-2 gene located on 9p24. This results in the continuous activation of JAK2 tyrosine kinase. PCM1-JAK2–positive MPN is a rare disease characterized by an aggressive course and resistance to therapy.
A 35-year-old male presented with a several-weeks history of abdominal discomfort, early satiety, low-grade fever, night sweats, and weight loss. Physical examination revealed pale skin and a massive hepatosplenomegaly. A complete blood count showed severe anemia, thrombocytopenia, and marked leukocytosis (100 000/μL) with 10% blasts, eosinophilia (4000/μL), and basophilia (3000/μL). Peripheral smear demonstrated blasts (panel A), early myeloid precursors (panels A-C), eosinophilia (panels A-C), and basophilia (panel C). Bone marrow biopsy showed myeloid lineage hyperplasia. Cytogenetic analysis was significant for t(8;9)(p22;p24). Testing for JAK2 mutation was negative, and FISH analysis failed to show BCR-ABL1 or any abnormality involving PDGFRA, PDGFRB, or FGFR1 genes. The patient was diagnosed with myeloproliferative neoplasm (MPN)-unclassified after excluding other hematologic neoplasms and causes of eosinophilia/basophilia.
Translocation t(8;9)(p22;p24) has been described to activate JAK2, resulting in a variety of diseases that surpass MPN to include cases of acute leukemia, lymphoma, and myelofibrosis. At the molecular level, t(8;9)(p22;p24) results in a new fusion gene product, putting the pericentriolar material 1 (PCM1) gene located on 8p22 in close proximity with the JAK-2 gene located on 9p24. This results in the continuous activation of JAK2 tyrosine kinase. PCM1-JAK2–positive MPN is a rare disease characterized by an aggressive course and resistance to therapy.
For additional images, visit the ASH IMAGE BANK, a reference and teaching tool that is continually updated with new atlas and case study images. For more information visit http://imagebank.hematology.org.
This feature is available to Subscribers Only
Sign In or Create an Account Close Modal